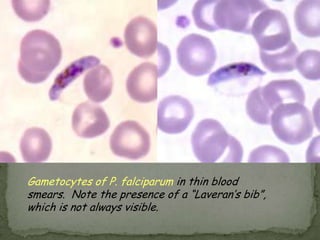
the trophozoite is the only stage in stoolsTrophozoites have characteristically one or two nuclei Life Cycle:
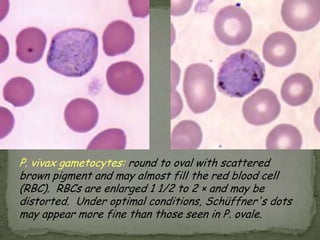

The document summarizes several intestinal protozoan parasites that can infect humans. It describes the causal agents, life cycles, transmission routes, clinical features, laboratory diagnosis, and treatment for parasites including Entamoeba histolytica, Giardia lamblia, Cryptosporidium parvum, Cyclospora cayetanensis, and Balantidium coli. Key details provided on each parasite include their geographic distribution, sites of infection within the host, symptoms caused, and diagnostic microscopic stages observed in stool samples.